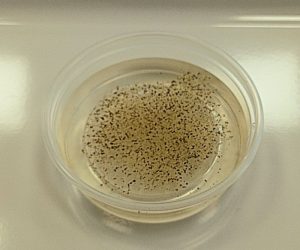

Podczas zajęć z laboratorium chemiczno-biologicznego uczniowie mieli okazję do rozwijania swoich zainteresowań poprzez samodzielnie wykonywanie licznych doświadczeń.
Eksperymenty prowadzone były pod bacznym okiem prowadzącego, zgodnie z otrzymanymi instrukcjami. Niektóre doświadczenia wymagały dużej cierpliwości oraz zręczności.
W trakcie lekcji uczniowie badali właściwości wody – wykonali szereg ciekawych i barwnych eksperymentów dotyczących m.in. zjawiska napięcia powierzchniowego, sił kohezji i adhezji, wpływu temperatury na prędkość cząsteczek oraz gradientu stężeń.
Prowadzący: Małgorzata Nowak-Mozoła